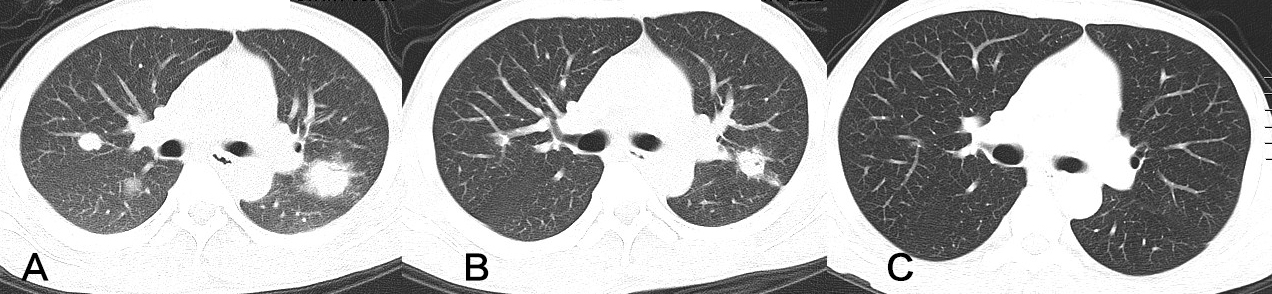

IFAP syndromeis a rare autosomal recessive X-linked disease characterized by the triad of alopecia universalis, severe photophobia, and follicular ichthyosis. It is caused by loss of function of the gene MBTPS2. Its severity varies and there are only a few reports in the literature. We present a patient with characteristic clinical features.
Continue readingVolume 1 Issue 4 - 2020
Voriconazole-Related Myopathy in a Liver Failure Patient: A Case Report
Voriconazole (VRC) is a broad-spectrum triazole antifungal drug and first-line choice for invasive pulmonary aspergillus (IPA) even in patients with liver failure. But it is limited when used in these individuals due to hepatoxicity and supratherapeutic trough plasma concentrations that could lead to severe adverse events appear or aggravate.
Continue readingKleine Levine syndrome (Sleeping beauty): A case report from Saudi Arabia
Background: Kleine – Levin syndrome (KLS), also called “Sleeping beauty syndrome” is a rare sleep disorder characterized by recurrent episodes of hypersomnia, hyperphagia, cognitive disturbances, and hypersexuality.
Continue readingChronic Pancreatitis-Induced Colonic Obstruction Mimicking a Stenosing Neoplasm at the Proximal Descending Colon: Treatment by Diverting Colostomy and Serial Pancreatic Duct Stenting

Large bowel obstruction mimicking colon cancer is a rare complication of acute or chronic pancreatitis. We present a case of a 42-year-old male patient with chronic alcoholic pancreatitis presenting with abdominal distension for two months...
Continue readingImmunotherapy in Endocrine Responsive Metastatic Breast Cancer

Immunotherapy has shown great benefit in multiple tumour types like melanoma and lung cancer. Although breast cancer was previously not considered an immunogenic disease...
Continue reading
Brachial Plexus Schwannoma: Case Report

Schwannomas, also known as neurinomas are benign, solitary nerve sheath neoplasm. When they occur in the head and neck, in 25–45 % ofcases,they usually develop in cranial nerves and the sympathetic chain with relative...
Continue reading





